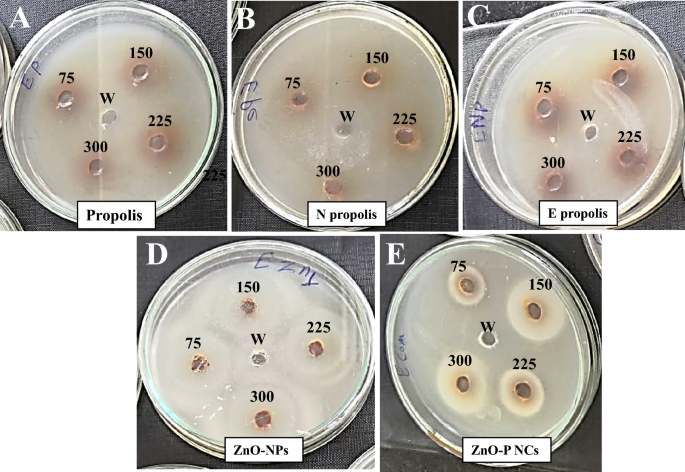
Fig. 8
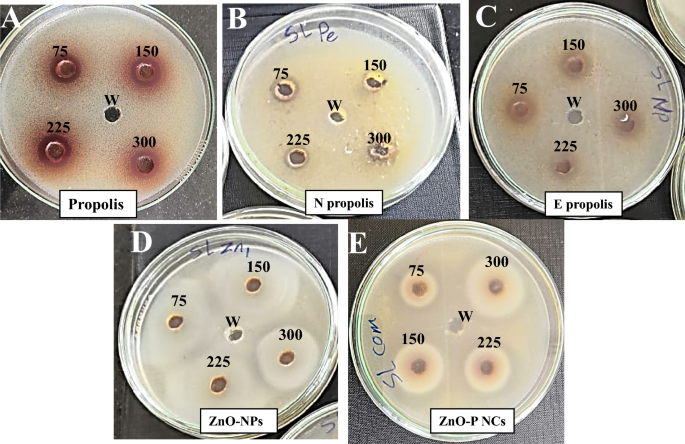
Fig. 9
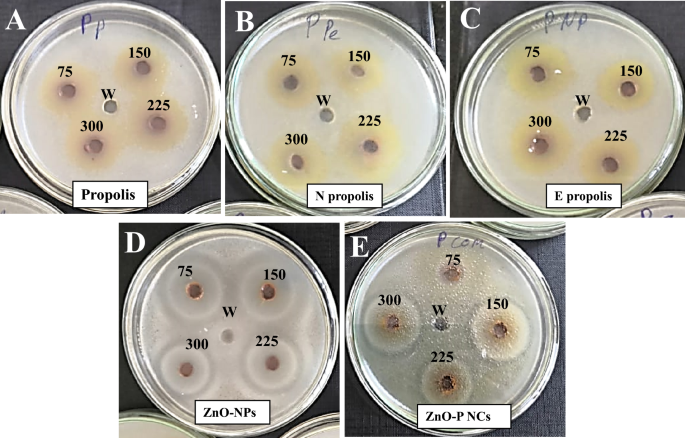
Fig. 10
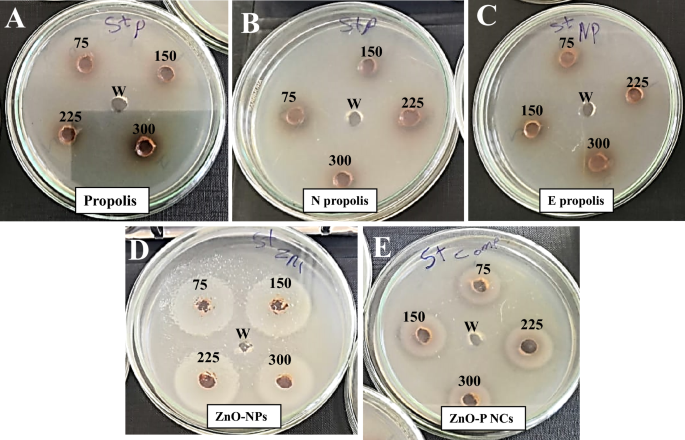
Fig. 11
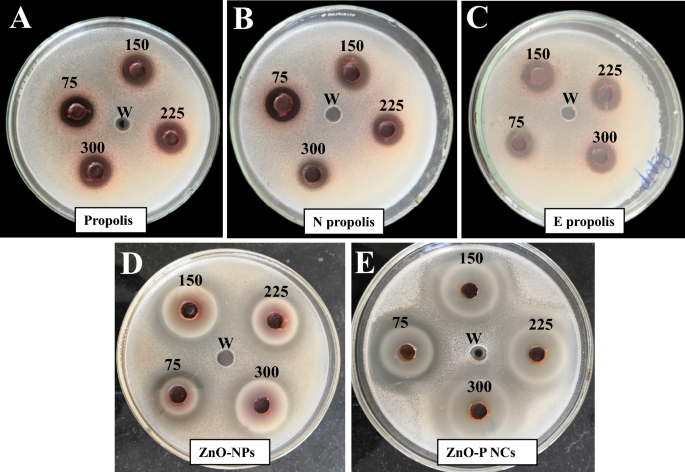
Fig. 12

Abstract
This study proposes an innovative approach to combat the escalating threat of antibiotic resistance in bacteria by introducing a novel ZnO-propolis nanocomposite (ZnO-P NCs). The overuse of antibiotics, particularly during events like the COVID-19 pandemic, has intensified bacterial resistance, necessitating innovative solutions. The study employs a cost-effective and controllable biosynthesis method to produce ZnO nanoparticles (ZnO-NPs), with propolis extract crucially contributing to the reduction and stabilization of Zn2+ ions. A biodegradable nano-propolis matrix is then created by incorporating ZnO-NPs, forming the ZnO-P NCs. Structural stability is confirmed through FT-IR and Zeta potential analysis, while nanoscale properties are validated via TEM, SEM, and XRD analyses. The antimicrobial efficacy of various substances, including propolis, nano propolis, ethanolic propolis extract, ZnO-NPs, and ZnO-P NCs, is assessed against Gram-negative and Gram-positive bacteria, alongside a comparison with 28 antibiotics. Among the bacteria tested, Pseudomonas aeruginosa PAO1 ATCC15692 was more sensitive (40 mm) to the biosynthesized nanocomposite ZnO-P NCs than to ZnO-NPs (38 mm) and nanopropolis (32 mm), while Escherichia coli was resistant to nanopropolis (0 mm) than to ZnO-NPs (31 mm), and ZnO-P NCs (34 mm). The study reveals a synergy effect when combining propolis with green-synthesized ZnO-NPs in the form of ZnO-P NCs, significantly improving their efficiency against all tested bacteria, including antibiotic-resistant strains like E. coli. The nanocomposite outperforms other materials and antibiotics, demonstrating remarkable antibacterial effectiveness. SEM imaging confirms the disruption of bacterial cell membranes by ZnO-NPs and ZnO-P NCs. The study emphasizes the potential applications of ZnO-NPs integrated into biodegradable materials and underscores the significance of the zinc oxide-propolis nanocomposite in countering antimicrobial resistance. Overall, this research offers a comprehensive solution to combat multidrug-resistant bacteria, opening avenues for novel approaches in infection control.
Similar content being viewed by others
Introduction
In light of the growing threat posed by drug-resistant bacteria and the infections they cause, there is an urgent need for a comprehensive and effective response. Rampant antibacterial resistance highlights the urgent need for innovative therapeutic approaches propagated through the injudicious application of antibiotics, as exemplified by the widespread antibiotic usage during the COVID-19 pandemic1. In combating the escalating challenge posed by antibiotic-resistant Escherichia coli (E. coli), ongoing research and development endeavors are imperative2. The emergence of multidrug-resistant strains necessitates the exploration of novel treatment modalities, encompassing innovative drug targets, combination therapies, and non-antibiotic approaches3,4. Therefore, ZnO, as a versatile inorganic material, is acknowledged for its intrinsic antimicrobial properties, ZnO has been extensively harnessed in various forms to counteract bacterial, fungal, and viral infections5,6. Likewise, the integration of ZnO-NPs into a nano-composite configuration augments its antimicrobial efficacy, attributed to heightened surface area and reactivity7. Alongside, propolis, a natural resinous substance collected by honeybees from plant sources, has antimicrobial, antioxidant, and anti-inflammatory properties8 due to its enrichment with an intricate blend of bioactive constituents (e.g. flavonoids, phenolic acids, and terpenes)9. The transformation of propolis into nanoparticles and their subsequent inclusion in a nano-composite matrix facilitates improved bioavailability and controlled release of its bioactive elements10.
Notably, the combination of ZnO-based compounds and propolis has demonstrated remarkable antimicrobial potential. In parallel, the amalgamation of ZnO and propolis within a nano-composite framework presents a promising avenue of investigation with multifaceted benefits.
Nanotechnology achieved the most significant breakthrough in recent years. So, it is expected that the confluence of ZnO and propolis within a nano-composite precipitates synergistic enhancement of their antimicrobial attributes, expanding their scope to encompass an array of microorganisms spanning bacteria, fungi, and beyond. The introduction of ZnO-NPs has a physical perturbation mechanism wherein microbial cell walls or membranes are susceptible to structural compromise, culminating in cellular demise11. This is complemented by propolis nanoparticles’ inhibitory actions on microbial growth and inflammation, which are concomitant with their support of wound-healing processes12. The dimensionality of nanoparticles confers penetration advantages into various tissues13, enabling augmented interaction with microbial entities and elevating the overall efficacy of the ZnO-propolis synergy.
However, it is important to underscore that the optimal formulation, dosing regimen, and safety parameters of the ZnO-propolis nano-composite necessitate meticulous research and development. Rigorous investigations are essential to unravel the precise mechanisms of action, long-term stability, and potential interactions within biological systems. This promising innovation, residing at the intersection of nanotechnology and antimicrobial therapy, holds the potential to instigate a paradigm shift in the pursuit of efficacious clinical interventions against antibiotic-resistant bacteria.
In conclusion, the contributions of this research are dual-pronged: Firstly, it unveils the finesse of synthesizing ZnO-NPs and their seamless integration into cutting-edge biodegradable matrices, thereby establishing a trajectory for multifarious applications. Secondly, it introduces an efficacious and transformative ZnO-propolis nanocomposite, emblematic of an innovative therapeutic approach countering the specter of multidrug-resistant bacteria. Negotiating the contemporary exigencies of infection control, this research transcends the boundaries of bacterial resistance, catalyzing a paradigm shift in the pursuit of clinically impactful interventions.
Methodology
Materials
All solutions have been formulated with Milli-Q water. Zinc nitrate, Zn (NO3)2.6H2O (M.W. 297.49), was acquired from Oxford Laboratory Reagent. Sodium hydroxide (NaOH), aluminum chloride (AlCl3), sodium nitrite (Na2NO3), Folin–Ciocalteau reagent, Gallic acid, and catechin were all purchased from Sigma Aldrich (St. Louis, MO, USA). Sodium carbonate (Na2CO3) is available from El-Nasr Pharmaceutical Chemicals in Cairo, Egypt. Carlo Erba Reagent provided doxorubicin and hydrochloric acid (HCl). After ripening in August and October (seasons 2021), propolis was collected from honeybee (Apis mellifera) colonies reared in modern hives in Tanta, El-Gharbya governorate, Egypt.
Preparation of propolis nanoparticles
Propolis was size-reduced to nanoparticles utilizing a ball mill as a top-down method. The unprocessed propolis was put into a stainless steel ball mill container with ceramic balls that ranged in diameter from 1.11 to 1.75 cm and were weighted 10:1 by propolis to the vessel. The container was revolved using ball mill equipment (photon, Egypt) for 24 h at 900 rpm. The created powder was collected.
Green synthesis of ZnO-NPs using propolis
ZnO-NPs are formed using a modified version of the co-precipitation approach14. Twenty g of propolis was boiled with 200 ml milli-Q water at 100 °C for 10 min using a magnetic stirrer heater. The liquid portion was removed using a pipette and filtered through filter paper. 2.98 g of Zn (NO3)2.6H2O was added to 100 ml of the obtained extract using a magnetic stirrer at room temperature, and the mixture was stirred for 1 h. The color change was noticed, confirming the reaction. The pellet was obtained after the fluid had been centrifuged at 8000 rpm for 15 min. The resultant pellet underwent three rounds of centrifugation while being suspended in distilled water, and it was then dried at 40 °C. ZnO-NPs are obtained in powder form. This powder is mashed in a ceramic mortar pestle to get a finer nature. Figure 1 depicts the process of making ZnO-NPs using propolis.
Green synthesis method of ZnO-NPs using propolis.
ZnO-propolis nanocomposite preparation
ZnO-P NCs were synthesized by repeating the procedures for preparing ZnO-NPs. Five grams of the synthesized nano-propolis were added to the medium for 1 h before precipitation in the presence of ultrasound. The generated ZnO-NPs were deposited directly on the surface of propolis nanoparticles forming ZnO-P NCs. The solution was then filtered, washed thoroughly several times, and dried at 40 °C.
Characterization
The PANalytical X-ray diffractometer (Empyrean) was utilized to conduct XRD analysis using Cu K radiation with a wavelength of 40 kV, scanning at a rate of 0.02 min−1 from 0° to 80° (2θ), and operating the device at a current of 35 mA and a voltage of acceleration of 40 kV. Bruker-Vertex 70 was used to conduct FTIR spectra. Field emission scanning electron microscopy (FESEM) and a transmission electron microscope (TEM) were used to analyze the morphology of the synthesized nanoparticles. The microstructure and surface morphology of green Zn and Zn-P NCs were studied using HRTEM (JOEL JEM-2100) at accelerating voltage (200 kV). Zetasizer Nano (Malvern Instruments Ltd., UK) assessed zeta potential and the hydrodynamic particle size. The method for preparing samples for zeta potential measurement was described in earlier work15. The band gap of the samples was calculated from the respective absorption edge by using an ultraviolet–visible spectrophotometer. Furthermore, FESEM was employed to detect the antibacterial effect of prepared ZnO-propolis nanocomposite (ZnO-P NCs) against Staphylococcus aureus and E. coli after 2, 6, and 12 h.
Total phenolic and flavonoid content determination
The Folin-Ciocalteu technique was used to measure the total phenolic contents of nano-propolis and the synthetic nanoparticles16. Aliquots of 0.1 g of lyophilized propolis powder and the synthesized nanoparticles were dissolved in 1 ml of distilled water. 0.1 ml of this solution was mixed with 0.1 ml of the 50% Folin–Ciocalteau reagent, 2 ml of sodium carbonate (Na2CO3), and 2.8 ml of distilled water. After 30 min of incubation, the reaction mixture’s absorbance at 30 nm was determined using a spectrophotometer (Hitachi, Model 100–20) against distilled water blank. As a standard, gallic acid was used. Using the five-point standard curve (0–250 mg/l), total phenolic contents in propolis and the synthesized nanoparticles have been measured in triple, respectively. The calculation was expressed in milligrams of gallic acid equivalents (GAE)/g). According to17, the total flavonoid content was measured using the aluminum chloride colorimetric method. In 1 ml of distilled water, aliquots 0.1 g of the synthesized nanoparticles and propolis were separately dissolved. 5 ml of the resultant solution was combined with 2.8 ml of distilled water, 1.5 ml alcohol (95%), 0.1 ml aluminum chloride (AlCl3) (10%), and 0.1 ml potassium acetate (CH3COOK) (1 M). The reaction mixture’s absorbance was measured at 415 nm against a distilled water blank using a spectrophotometer (Hitachi, Model 100–20) after a 40-min incubation period at room temperature. The standard was selected to be quercetin. Using the five-point standard curve (0–75 mg/l) in triplicate, the amounts of total flavonoid content in the samples were each measured. It was presented in milligrams of quercetin equivalents (QE) per gram of lyophilized powder.
Antimicrobial activity
Bacterial strains
Gram-negative bacteria
Three species of gram-negative bacteria E. coli O:157 ATCC 1659, Salmonella typhi ATCC 13,076, and P. aeruginosa PAO1 ATCC15692.
Gram-positive bacteria
Two species of gram-positive bacteria Bacillus cereus ATCC 11,778 and S. aureus ATCC 13,565.
All strains mentioned above were obtained as actively growing cultures from the microbial culture collection of the Microbiological Resources Centre Cairo (MIRCEN), Faculty of Agriculture, Ain Shams University, Cairo, Egypt.
Agar well-diffusion method
The antimicrobial activity of propolis, nano propolis, propolis extract, ZnO-NPs, and ZnO-propolis was examined against five bacteria selected based on their relevance to public health. 10 µL of each fresh bacterial culture at a concentration of 105 CFU/ml were inoculated in molten sterile nutrient agar medium (NA), which contains peptone 5 g, yeast extract 5 g, beef extract 3 g, agar 20 g, 1 L of distilled water at the medium pH was perfect to be 7. Wells of 5 mm diameter were made by a sterile tip made of polystyrene on the agar plates. Various concentrations such as 75, 150, 225, and 300 µg of propolis, nanopropolis, propolis extract, ZnO-NPs, and ZnO-propolis were added to separate wells. The negative control used in the tests was the water. The Petri plates containing the inoculated samples were sealed with Parafilm and then placed in a microbial incubator set at 37 °C for 24 h. Afterward, the inhibition zones were measured to assess and analyze the potential impact of propolis, propolis extract, nanopropolis, ZnO-NPs, and ZnO-propolis. The antimicrobial activity was determined based on four separate replicates.
The antimicrobial activity of commercial antibiotics compared with nanopropolis, ZnO-NPs, and ZnO-propolis
The disc diffusion method is a widely used technique for assessing the susceptibility of bacteria to various antibiotics18. In this method, antibiotic-impregnated discs were placed onto the surface of an agar plate that had been inoculated with the 5 tested bacteria. Table 1 demonstrates the 28 commercial antibiotics that were used as standard antibiotics to control the sensitivity of the tested bacteria for comparison. These antibiotics were obtained from (Pasteur Lab, Egypt). The data is expressed as the diameter of the growth inhibition zone in millimeters. The diffusion of the antibiotic from the disc into the agar created a concentration gradient, which allows for the evaluation of the bacterial sensitivity to the antibiotic. Appropriate agar plates, such as nutrient agar, were prepared and allowed to solidify. The tested bacteria of 106 CFU/ml concentration were swabbed over the surface of the agar plate. This is typically done with a sterile cotton swab. Subsequently, the agar plates were placed in an incubator at 37 °C for 24 h. During this time, the antibiotic diffuses into the agar, creating a concentration gradient surrounding the discs. After incubation, the plates were examined. The inhibition zones around each disc were calculated in millimetres. The size of the zones of inhibition is compared to nanopropolis, ZnO-NPs, and ZnO-propolis at a concentration of 300 µg.
Determination of the minimum inhibitory concentration (MIC) and minimal bactericidal concentration (MBC) of propolis, nanopropolis, propolis extract, ZnO-NPs, and ZnO-propolis
Minimum Inhibitory Concentration (MIC) The broth dilution method was used to determine the MIC of propolis, nanopropolis, propolis extract, ZnO-NPs, and ZnO-propolis, following the protocol described by19. The extracts were diluted in Mueller Hinton broth to concentrations of 750, 500, 400, 250, 100, 75, 50, 40, and 30 µg/mL. Each dilution was inoculated with 105 CFU/mL of bacterial culture. Control tubes without bacterial inoculation were maintained. The tubes were incubated anaerobically at 37 °C for 24 h. The MIC was defined as the lowest concentration of the extract that inhibited visible bacterial growth (i.e., no turbidity).
To increase the precision of the MIC determination, a more refined concentration gradient was applied using the agar dilution method.
Minimum Bactericidal Concentration (MBC) To determine the MBC, 100 µL of the samples from the MIC assay that showed no visible growth were inoculated onto fresh Mueller–Hinton agar plates without any antimicrobial agents. The inoculated samples were evenly spread using a sterile loop. The agar plates were then incubated at 37 °C for 24 h. After incubation, the plates were examined for bacterial colonies. The MBC was defined as the lowest concentration at which no bacterial colonies were observed.
By following these procedures, we ensured the accuracy and reliability of the MIC and MBC values for the tested compounds.
Scanning electron microscopy (SEM) analysis
Preparation and treatment of bacterial cells
Escherichia coli and S. aureus bacterial cultures were grown to the mid-logarithmic phase in Mueller–Hinton broth at 37 °C. The cultures were then divided into control and treatment groups. For the treatment groups, ZnO-propolis nanocomposite was added to the bacterial suspensions to achieve a final concentration based on the Minimum Inhibitory Concentration (MIC) determined in previous experiments.
-
1.
Sample preparation
-
Control samples (without ZnO-propolis nanocomposite) and treated samples were incubated for varying time points (2 h, 6 h, and 12 h).
-
After incubation, bacterial cells were harvested by centrifugation at 3000 rpm for 10 min.
-
The cell pellets were washed twice with phosphate-buffered saline (PBS, pH 7.4) to remove any residual media or non-bound nanocomposite.
-
2.
Fixation
-
The washed cell pellets were fixed with 2.5% glutaraldehyde in PBS for 2 h at room temperature to preserve the cellular structures.
-
Fixed cells were washed again with PBS and then subjected to a dehydration series using increasing concentrations of ethanol (30%, 50%, 70%, 90%, and 100%) for 10 min each.
-
3.
Drying and coating
-
Dehydrated samples were dried using a critical point dryer to avoid any structural collapse.
-
The dried samples were mounted onto SEM stubs and sputter-coated with a thin layer of gold to enhance conductivity.
-
4.
Imaging
-
SEM imaging was performed using a scanning electron microscope at an accelerating voltage of 15 kV.
-
Multiple fields were examined to ensure representative imaging of the bacterial cells.
Statistical analysis
A one-way analysis of variance (ANOVA) was conducted at a significance level of p < 0.05 to assess the differences, followed by the implementation of the Tukey test using the software tool Origin (2019). The analysis encompassed four replicates for each set of data, ensuring a robust evaluation.
Ethical approval and consent to participate
Not Applicable as the study not applied on human or animals study. The article does not include any studies on human participants or animals conducted by any of the authors.
Results and discussion
Characterization
XRD analysis
As seen in Fig. 2a, the x-ray diffractogram analysis was used to examine the structural composition of propolis extract, ZnO-NPs, and ZnO-propolis. Propolis’s wide variety of chemical components frequently result in amorphous or weakly crystalline formations. The pure propolis structural pattern is observed in the area 2θ = 21.5°, according to works of literature20. According to published literature, ZnO-NPs XRD patterns revealed semi-crystalline structures with 2θ at 34.5°, 36.4°,44.2°,48.1°,57.12°, and 63.2°, indexed to (002), (101), (012), (100), (102), and (103), respectively21,22. ZnO-propolis patterns showed decreased intensity peaks for both propolis and ZnO, suggesting the formation of a ZnO-propolis nanocomposite. X-ray diffraction (XRD) data is frequently used to determine the crystallite size (D) of nanomaterials using the Debye–Scherrer equation. The crystallite size is related to the scattering angle (θ), the complete width at half maximum of the XRD peak (β), and the X-ray wavelength (λ) in the equation.
(a) XRD patterns and (b) FTIR characteristics of propolis, ZnO-NPs, and ZnO-propolis.
The computed crystallite size of the ZnO-propolis nanocomposite at the high-intensity peak (2θ = 21.1°) is 9.70 nm based on the given formula and parameters. The average size of the crystalline domains inside the nanocomposite material, as deduced from the XRD investigation, is provided by this estimation.
Fourier transform infrared (FT-IR) spectroscopy
The FT-IR spectroscopy technique was applied to study the chemical compositions and structures of propolis extract, ZnO-NPs, and ZnO-propolis (Fig. 2b). For propolis, A broad band at 3383 cm−1 is associated with the hydroxyl group (OH) molecule’s stretching vibrations that are present in flavonoids and the phenolic compounds and also associated with N–H stretching vibrations of amide bonds in propolis23,24. The stretching vibrations of the CH2 groups exhibit asymmetry at 2925 cm−1 and symmetry at 2852 cm−1 arising from organic substances that include hydrocarbon groups or aliphatic chains23. The carbonyl stretching vibrations (C=O) seen in substances like flavonoids and phenolic acids are shown by the peak at 1631 cm−125. The flavonoid family’s C-H stretching vibrations are represented by the absorption bands at 1453 cm−1 and 1376 cm−126. These peaks help identify flavonoids by indicating particular structural components that are present in them. A weak band at 1168 cm−1 is ascribed to alkene C=C bending vibrations27. The band at around 1021 cm−1, has C–O stretching vibrations, which are prevalent in ethers, alcohols, and esters, which are found in different propolis constituents28. Typically, bands about the stretching and bending vibrations of C–H from aromatic rings, specifically associated with phenolic chemicals, are detected within the 900–500 cm−1 range28. For the ZnO-NPs spectrum, a strong wide peak at 3131 cm−1 is ascribed to the stretching vibration of hydroxyl (OH) groups26. The 1561 cm−1 band is associated with the amide groups’ C=O stretching vibrations. The Band at 1444 cm−1 is linked to the –C–H bond’s bending vibration26. 1047 cm−1 band relates to the stretching vibration of C–O26. The bending vibrations of =C–H are assigned to the 955 cm−1 and 694 cm−1 bands. The stretching vibration of Zn–O bonds is responsible for the 457 cm−1, which ensures the creation of the product26,28,29. The ZnO-propolis spectrum contains the same bands of pure propolis with a small shift indicating the chemical interaction between ZnO and propolis. Also, the small band at 457 cm−1 indicates the presence of Zn–O bonds in the structure.
Morphological analysis
Figure 3 shows the morphological structures of the propolis extract, ZnO-NPs, and the ZnO-propolis analyzed by SEM and TEM. SEM micrographs of the propolis material, are shown in Fig. 3a; the particles have a size of a few hundred nanometers and have an uneven form due to agglomeration. ZnO-NPs in Fig. 3b exhibited smooth and semi-hexagonal structures. For ZnO-propolis, Fig. 3c, small nanoparticles with a roughly fair and uniform distribution devoid of empty or crack space on a wide scale.
SEM micrographs (a, b, and c), and TEM images (d, e, and f) of propolis extract, ZnO-NPs, and the ZnO-propolis respectively. (g) EDX for the ZnO-propolis nanocomposite.
The TEM images are shown in Fig. 3(d, e and f). The propolis’s TEM image shows agglomerated particles indicating that the sample’s constituent structures or particles have been clustered or aggregated, Fig. 3d. ZnO-NPs showed small spherical-shaped ZnO-NPs connected. The TEM image of ZnO-propolis in Fig. 3f shows the tiny spherical ZnO-NPs adhering to or connecting with the propolis nanosheets’ surface. The close bonding or tight attachment of these ZnO-NPs onto the propolis nanosheets suggests a strong interaction or bonding between the ZnO-NPs and the propolis material.
An energy dispersive X-ray (EDX) analysis, Fig. 3g, can be used to determine the elemental composition of a material. The elemental composition of the nanocomposite was shown by the EDX Spectra, indicating the presence of elements like zinc (Zn), carbon (C), oxygen (O), and maybe sodium (Na) and potassium (K) in the sample.
The dispersion of components throughout a sample’s surface utilizing this method was demonstrated by the EDX mapping study. The homogeneity and distribution of various elements, such as zinc, carbon, and oxygen, throughout the produced material, are shown in a map or image. This mapping demonstrates the uniform or even dispersion of these constituents throughout the material and confirms their geographical distribution.
Zeta potential (ZP) and size distribution
The zeta potential values of the generated nanomaterials can be used to assess their stability. Therefore, values of ZP between ± 30 mV are thought to be optimal for stabilizing nano-dispersion effectively. According to Fig. 4(a, b, and c), the zeta potential values of the propolis, ZnO-NPs, and the ZnO-propolis, were − 34 mV, − 11.8 mV, and − 27.1 mV, respectively. The nanocomposite showed higher stability compared to the pure propolis. Figure 5(a, b, and c) illustrates the measured particle size distributions for the propolis, ZnO-NPs, and the ZnO-propolis samples, which were 2119, 1601, and 1751 nm, respectively. It is confirmed that the nanocomposite has formed when the hydrodynamic size of the nanocomposite is greater than that of ZnO-NPs29. ZnO-propolis sample is similar in size to ZnO NP. It seems that a partial fragment of propolis is attached to the ZnO NP; this may be related to the green synthesis the particles have a capping agent from extracts used in the particle preparation, which increases the hydrodynamic size of ZnO NPs and near to the size of nanocomposite.
Zeta potential of (a) propolis extract, (b) ZnO-NPs, and (c) propolis.
Particle size distributions of (a) propolis extract, (b) ZnO-NPs, and (c) the ZnO-propolis.
The solution is considered stable when the materials’ zeta potential is within the range of − 30 to + 30 eV30. According to the data, the propolis has − 34 eV, which means that it is more negatively charged and less stable in the propolis solution. ZnO-NPs solution exhibited less negativity and a more stable system (− 11.8 eV). Given that the ZnO-propolis’s zeta potential is − 27 eV, it is more logistic to have propolis particles in the structure.
Optical properties
UV–Vis absorption patterns are critical for understanding the optical characteristics and energy structures of propolis, ZnO-NPs, and ZnO-propolis. The UV–Vis spectra in Fig. 6a shows a clear absorbance peak for propolis material at around 277.7 nm. Figure 6b shows an absorbance peak at 278.8 nm for ZnO-NPs. Figure 6c shows an absorbance peak of ZnO-propolis at around 280 nm. The occurrence of ZnO-propolis nanocomposite having an absorption peak at a slightly higher wavelength compared to ZnO-NPs can be defined as a “red shift” in terms of spectral alterations31. The red shift may result from a variety of processes, including modifications to the nanoparticles’ size, shape, or surface characteristics after they are added to the nanocomposite. Additionally, it might imply that the ZnO-NPs and other elements of the nanocomposite interact or form chemical bonds, changing the energy levels and ultimately influencing the absorption properties31. The information provided explains how the optical bandgap energies for propolis, ZnO-NPs, and ZnO-propolis nanocomposite (inset images) were calculated using the Tauc equation.
α is the coefficient of absorption. The incident light energy is represented by hv, which is computed using the formula hν = 1240/λ, where λ is the incident light’s wavelength. B is an absorbance-related constant. Eg stands for band gap energy. The transition mode is represented by the constant m32,33,34. Propolis, ZnO-NPs, and ZnO-propolis had band gap energies of 2.37 eV, 2.89 eV, and 2.66 eV, respectively, which were determined based on the data that was supplied. The observed patterns indicate that the band gap energies rise when the particle size or composite structure increases from propolis to the nanocomposite. Changes in the material’s composition, size, morphology, or interactions between its constituent parts may all be responsible for this rise in band gap energy. In accordance with Eq. (1) below, which defines the relationship between particle size (a) and band gap (Eg), Researchers investigated how size affected band gap, and their findings indicate that band gap rises as size decreases35,36
UV–vis absorption spectra and thus plots for bandgap energy (inserted images) of (a) propolis, (b) ZnO nanoparticles, and (c)ZnO-propolis.
.
(where Ebulk represents the bulk band gap, ΔE pertains to the phenomenon of quantum confinement, me* denotes the effective mass of an electron, mh* signifies the effective mass of a hole, and h refers to Planck's constant). The reason for this is due to quantum confinement effects, which occur when a nanoparticle decreases in size and contains more electrons and holes in a smaller volume. This confinement results in a rise in the energy difference, or band gap, between the valence band and the conduction band. Because of this, band gaps are generally higher in smaller than in larger nanoparticles of the same material35,36. This results correlate with our band gab and zeta size.
Antimicrobial activity of propolis, nano propolis, propolis extract, ZnO nanoparticles, and ZnO-propolis
The antimicrobial activity was tested using an agar well diffusion assay. The antibacterial effect of propolis, nano propolis, propolis extract, ZnO nanoparticles, and ZnO-propolis was visualized against five pathogens like E. coli, S. typhi, and P. aeruginosa, B. cereus, and S. aureus, which was drawn in Figs. 7, 8, 9, 10, 11 and 12. Results demonstrate that biosynthesized nanopropolis, ZnO nanoparticles, and ZnO-propolis increase in a dose-dependent manner. The antimicrobial properties of propolis are primarily attributed to its positive charges, which disrupt the negatively charged components of macromolecules on the surface of microbial cells. This disruption leads to membrane leakage37. Among the tested bacteria, E. coli showed higher susceptibility and proved to be the most resistant among all. Figures 7C–E and 8A–C showed that when propolis, nanopropolis, and propolis extract were used, there was no inhibition observed in the growth of E. coli, while it was sensitive bacteria for ZnO nanoparticles and ZnO-propolis (Figs. 7A, B and 10D, E). From Fig. 7, P. aeruginosa is the most sensitive to propolis, nanopropolis, and propolis extract, however, S. typhi, S. aureus and B. cereus are resistant, whereas E. coli was not affected at all. So raw propolis, nanopropolis, and propolis extract represent the least effective compounds in achieving the antibacterial effect the antimicrobial activity compared with the other agents used in our study, but ZnO nanoparticles, and especially ZnO-propolis, have been recorded to show antimicrobial effects in the laboratory (vitro) against all tested pathogens38,39 (Fig. 8). The antimicrobial effect of ZnO nanoparticles and ZnO-propolis can be attributed to their ability to hinder the DNA and RNA synthesis within bacterial cells. Additionally, they have the potential to disturb the functionality of bacterial cytoplasmic membranes and disrupt the energy metabolism of bacteria40. Several studies have demonstrated that ZnO nanoparticles can effectively hinder the proliferation of various pathogenic bacteria. These include Salmonella enteritidis, Vibrio parahaemolyticus, E. coli, Listeria monocytogenes, and Salmonella typhimurium41,42,43.
Antimicrobial activity of (A) ZnO nanoparticles, (B) ZnO-propolis, (C) propolis, (D) nanopropolis, and (E) propolis extract. Vertical bars represent the means ± standard deviation (means ± SD) of three replicates (n = 3).
Determination of inhibition zones of (A) propolis, (B) nanopropolis, (C) propolis extract, (D) ZnO nanoparticles, and (E) ZnO-propolis against E. coli.
Determination of inhibition zones of (A) propolis, (B) nanopropolis, (C) propolis extract, (D) ZnO nanoparticles, and (E) ZnO-propolis against S. typhi.
Determination of inhibition zones of (A) propolis, (B) nanopropolis, (C) propolis extract, (D) ZnO nanoparticles, and (E) ZnO-propolis against P. aeruginosa.
Determination of inhibition zones of (A) propolis, (B) nanopropolis, (C) propolis extract, (D) ZnO nanoparticles, and (E) ZnO-propolis against S. aureus.
Determination of inhibition zones of (A) propolis, (B) nanopropolis, (C) propolis extract, (D) ZnO nanoparticles, and (E) ZnO-propolis against B. cereus.
We found that ZnO-propolis was effective against all tested bacteria and this effectiveness increased with increasing in its dose to reach its maximum inhibition zone at 300 µg (Fig. 7B). At a concentration of 300 µg of ZnO nanoparticles, E. coli was the most resistant, while P. aeruginosa was the most sensitive as shown in Fig. 7A.
The antimicrobial activity was measured by assessing the inhibition zones for each compound against the tested bacterial strains. The data demonstrate the comparative effectiveness of each treatment in inhibiting bacterial growth, with ZnO-propolis showing the most significant activity across all tested microorganisms.
Comparison of nanopropolis, ZnO-NPs, and ZnO-propolis antimicrobial activity with 28 different commercial antibiotics
The antibacterial effect of nanopropolis, ZnO-NPs, and ZnO-propolis was visualized against five pathogens: E. coli, S. typhi and P. aeruginosa, B. cereus, and S. aureus, which was drawn in Fig. 13. Results demonstrate that biosynthesized nanopropolis, ZnO-NPs, and ZnO-propolis increase in a dose-dependent manner. The ZnO-propolis is the most effective against all tested bacteria. Whereas S. typhi is the most sensitive in contrast to E. coli, and B. cereus are resistant while P. aeruginosa and S. aureus have moderate effects. In general, ZnO-NPs had a higher antimicrobial effect than propolis extract, followed by nano-propolis, and propolis, respectively. It was noted that when ZnO-NPs were combined with nanopropolis in the nanocomposite, a synergy effect appeared, and the antimicrobial effect of ZnO-propolis nanoparticles was the highest ever.
Inhibition zone diameter (mm) of (A) E. coli, (B) S. typhi, (C) P. aeruginosa, (D) S. aureus, and (E) B. cereus treated with antibiotics compared with nanopropolis, ZnO-NPs, and ZnO-propolis. Vertical bars represent the means ± standard deviation (SD) of three replicates (n = 3).
Escherichia coli has evolved a range of antibiotic resistance mechanisms, enabling it to resist the actions of numerous antibiotics. It has exhibited resistance to 9 out of 28 tested antibiotics as shown in (Fig. 13A). Interestingly, ZnO-NPs have demonstrated greater potency than most antibiotics, except for kanamycin, imipenem, nalidixic acid, and norfloxacin. Notably, nanopropolis exhibited no inhibitory effect on E. coli, consistent with findings from44,45,46,47,48.
When ZnO-NPs and nano propolis were combined, synergistic interactions were observed, amplifying their antibacterial properties. The resulting ZnO-propolis exhibited the highest inhibitory effect on resistant E. coli, effectively enhancing the initially absent effect of nanopropolis and complementing the action of ZnO-NPs through synergy. This synergy effect between ZnO-NPs and nanopropolis in their composite formulation indicates that the combined impact of these two components surpasses the sum of their individual effects, leading to a significantly enhanced overall biological activity.
Salmonella typhi exhibits resistance to 7 out of 28 tested antibiotics, as illustrated in (Fig. 13B). Interestingly, nanopropolis demonstrated a moderate bactericidal effect, yielding an inhibition zone diameter of 18 mm. In contrast, ZnO-NPs displayed robust bactericidal activity against S. typhi, resulting in a notable 34 mm inhibition zone diameter. Remarkably, the treatment involving the ZnO-propolis revealed a synergistic antibacterial effect against S. typhi, characterized by an expansive 40 mm inhibition zone. Notably, this combined effect surpassed the efficacy of all 28 antibiotics, except for kanamycin.
In Fig. 13C P. aeruginosa is resistant to 14 antibiotics out of 28 antibiotics. However, nanopropolis had a high bactericidal activity with a 30 mm Inhibition zone diameter. ZnO-NPs had strong bactericidal activity against P. aeruginosa with a 38 mm Inhibition zone diameter, in contrast, a synergistic antibacterial activity against P. aeruginosa was observed in ZnO-propolis treatment with 40 mm, it was more potent than the effect of all 28 antibiotics.
Staphylococcus aureus is resistant to 8 antibiotics out of 28 antibiotics as shown in Fig. 13D, however, nanopropolis had moderate bactericidal activity with an 18 mm Inhibition zone diameter. ZnO-NPs had strong bactericidal activity against S. aureus with a 30 mm Inhibition zone diameter, in contrast, a synergistic antibacterial effect against S. aureus was observed in ZnO-propolis treatment with 38 mm, it was more potent than the effect of all antibiotics except imipenem.
Bacillus cereus demonstrates resistance to 11 out of the 28 tested antibiotics as illustrated in Fig. 13E. Impressively, nanopropolis displayed a high level of bactericidal activity, resulting in a substantial 20 mm inhibition zone diameter. Conversely, ZnO-NPs exhibited robust bactericidal activity against B. cereus, yielding a noteworthy 33 mm inhibiting zone diameter. Remarkably, the ZnO-propolis treatment revealed a synergistic antibacterial effect against B. cereus, characterized by an impressive 35 mm inhibition zone. Notably, this combined effect surpassed the efficacy of all 28 antibiotics.
Determination of the minimum inhibitory concentration (MIC) and the minimal bactericidal concentration (MBC) of propolis, nanopropolis, propolis extract, ZnO-NPs, ZnO-propolis
The MIC value can be affected by various factors for example temperature, the quantity of the initial microbial inoculation, and the specific type of microorganism involved49. Table 2 presents the MIC values, ranging from 30 to 500 g/mL for the evaluated compounds when tested against the selected microorganisms. The MIC of the propolis, nanopropolis, propolis extract, ZnO-NPs, and ZnO-propolis were determined against E. coli, S. typhi, P. aeruginosa, B. cereus, and S. aureus.
Regarding the propolis, it had an antibacterial effect against P. aeruginosa (100 µg/mL) but was less effective against S. typhi (500 µg/mL), S. aureus (250 µg/mL), and B. cereus (400 µg/mL). Otherwise, it had no antibacterial effect on E. coli at the tested concentrations. About the Nanopropolis, it was effective against S. typhi, P. aeruginosa, and S. aureus (100 µg/mL for each) with the highest superiority for the first, less effective against B. cereus (250 µg/mL) and S. typhi (400 µg/mL), and ineffective against E. coli. This indicates the antibacterial effectiveness of nanosized fractions of Propolis, enhancing its penetration into the bacteria cells. The Propolis Extract, had the highest effect against S. aureus (50 µg/mL), B. cereus (75 µg/mL), and P. aeruginosa (100 µg/mL) with the highest superiority in antibacterial effectiveness for the first, and less effective for S. typhi (400 µg/mL), while there was no antibacterial effect for E. coli. This signifies that the Propolis Extract has concentrated specific bioactive compounds, enhancing its antibacterial activity. On the other hand, ZnO-NPs are consistently effective across all tested bacteria with MIC values ranging from 50 to 75 µg/mL. This suggests its broad-spectrum antibacterial effect. Compared to ZnO-NPs, the ZnO-propolis exhibited the highest potency with the lowest MIC values across most bacteria: P. aeruginosa (30 µg/mL), S. typhi, and S. aureus (40 µg/mL each), E. coli (50 µg/mL), and B. cereus (50 µg/mL). Hence, the incorporation of ZnO-NPs in the prepared composite had an enhancing antibacterial effect against all bacteria, especially E. coli due to its reactive oxygen species (ROS). Moreover, the synergistic interaction between ZnO-NPs and propolis, enhances their specific antibacterial properties, resulting in the superior performance of ZnO-Propolis. The ZnO-Propolis likely benefits from both the ROS generation and membrane disruption by ZnO-NPs, and the bioactive compounds in propolis.
On the other hand, the MBC values (Table 3) showed that the Propolis, Nanopropolis, and Propolis Extract had weak bactericidal activity on S. typhi and P. aeruginosa. Moreover, they did not have any bactericidal effect on E. coil, suggesting limited use against certain gram-negative bacteria. Otherwise, propolis Extract had the highest bactericidal effect on S. aureus (75 µg/mL each) and B. cereus (100 µg/mL). This can be attributed to the concentration of bioactive compounds in the extract of Propolis as previously mentioned. Like ZnO-NPs, ZnO-propolis illustrated improved bactericidal impact against all bacteria strains with a slightly better bactericidal effect for the letter. This indicates that ZnO-NPs and ZnO-propolis are highly effective in killing both Gram-positive and Gram-negative bacteria. The synergistic impacts of ZnO-NPs and propolis in ZnO-propolis nanocomposite contribute to this enhanced bactericidal activity. This combination boosts the bactericidal mechanisms of both components, resulting in a more effective antimicrobial agent.
In particular, the antibacterial attributes of these active substances could be linked to their lipophilic nature. This characteristic may result in alterations in the membrane potential, heightened permeability of the cytoplasmic membrane to protons and potassium ions, and depletion of the intracellular ATP reservoir37. The antimicrobial characteristics of ZnO-propolis are linked to both the hydrolysis of peptidoglycan layers within the bacterial cell wall and perturbations in the bacterial cell membrane50,51.
According to the MIC and MBC, gram-negative bacteria are generally more resistant to antibiotics than gram-positive bacteria. This is because gram-negative bacteria have an outer membrane that acts as a barrier, making it more difficult for antibiotics to penetrate and disrupt the bacterial cell. Furthermore, bacteria with a Gram-negative cell wall structure often have efflux pumps that can pump antibiotics out of the cell, further contributing to their resistance. Nevertheless, it is crucial to emphasize that the level of antibiotic resistance can significantly differ across various bacterial species, and the precise mechanisms of resistance can vary. In the current study, the high value of MBC was recorded by S. typhi.
SEM analysis of ZnO-propolis nanocomposite activity against E. coli and S. aureus
Figures 14 and 15 show the results of incubating both control and treated E. coli and S. aureus strains for 2, 6, and 12 h. Figure 14 and 15A represents the negative control of bacterial strains without ZnO-propolis nanocomposite. Initial observations (after 2 h) revealed early indications of interaction between the ZnO-propolis nanocomposite and the bacterial cell surface. These interactions were characterized by minor surface irregularities (Figs. 14 and 15C), while no changes were observed in the control treatments (Figs. 14 and 15B). After 6 h, more pronounced morphological changes were observed, including membrane disruptions, pore formation, and changes in cell shape (Figs. 14 and 15E). No changes were observed also in the control treatments (Figs. 14 and 15D). Finally, in the later stages (12 h), advanced damage or cell death occurs, including cell lysis, significant surface degradation, and complete structural collapse (Figs. 14 and 15G). No morphological changes were observed in the control group (Figs. 14 and 15F).
SEM photographs showing the antibacterial effect of ZnO-propolis nanocomposite against E. coli. (A) Negative control (without ZnO-propolis nanocomposite); (B) Negative control (after 2 h); (C) Bacterial cells treated with ZnO-propolis nanocomposite (after 2 h), showing destruction and erosion of the cell wall; (D) Negative control (after 6 h); (E) Bacterial cells treated with ZnO-propolis nanocomposite (after 6 h), showing spheroplasts; (F) Negative control (after 12 h); (G) Bacterial cells treated with ZnO-propolis nanocomposite (after 12 h), showing complete destruction and loss of cell structure.
SEM photographs showing the antibacterial effect of ZnO-propolis nanocomposite against S. aureus. (A) Negative control (without ZnO-propolis nanocomposite); (B) Negative control (after 2 h); (C) Bacterial cells treated with ZnO-propolis nanocomposite (after 2 h), showing destruction and erosion of the cell wall; (D) Negative control (after 6 h); (E) Bacterial cells treated with ZnO-propolis nanocomposite (after 6 h), showing spheroplasts; (F) Negative control (after 12 h); (G) Bacterial cells treated with ZnO-propolis nanocomposite (after 12 h), showing complete destruction and loss of cell structure.
The combination of ZnO and propolis in a nanocomposite can synergistically enhance their antimicrobial properties and broaden their spectrum of activity against bacteria. The ZnO NPs physically damage the cell walls or membranes of microorganisms, leading to their disruption and death. Meanwhile, the bioactive compounds in propolis further inhibit microbial growth.
Important antibacterial activity mechanisms include the production of reactive oxygen species (ROS), the release of antimicrobial zinc ions, and electrostatic contact. As the primary mechanism of antibacterial activity, ROS production, particularly during specific wavelengths of light absorption, was suggested. ROS was produced using a variety of methods, including bacterial surface adsorption, electron/hole pair creation, interaction of the created pairs with oxygen and water, and formation of other intermediates. However, it has also been suggested that another effective antibacterial mechanism involves the production of antimicrobial ions like Zn+2 and the electrostatic interaction of NPs with microbes. The direct (production of ROS inside the bacterial cell) and indirect (generation of ROS outside the bacterial cell) approaches for the interaction of NPs with bacteria and the formation of ROS.
The nanocomposite formulation provides advantages such as increased stability, controlled release of active components, and improved targeting of specific sites or organisms. The small size of nanoparticles allows for better penetration into tissues and increased interaction with microbial cells, enhancing the effectiveness of the ZnO and propolis combination.
ZnO-NPs and propolis both exhibit antimicrobial properties. The combination of these two components in a composite can result in synergistic effects, leading to improved inhibition of a broad spectrum of microorganisms, including bacteria. The mechanisms of action involve multiple pathways, such as physical damage to microbial cell walls, disruption of essential cellular processes, and increased oxidative stress within the microorganisms.
Conclusion
In this research work, the ZnO-propolis composite was synthesized using propolis and ZnO NPs. Propolis nanocomposite has been combined with ZnO as a powerful stabilizing agent to create ZnO-propolis nanocomposite. The outcomes obtained from the ZnO-propolis demonstrated its efficacy as a potent antimicrobial material. Utilizing UV–Vis spectroscopy, SEM, and TEM analyses, the existence of elemental Zn in the nanocomposite was validated, showing a rod-like structure with dimensions ranging from 30 to 150 nm. Furthermore, the synthesized ZnO-propolis composite, incorporating propolis, was verified to enhance its antimicrobial effectiveness against a range of bacteria, including E. coli, S. typhi, P. aeruginosa, B. cereus, and S. aureus. Our current research focuses on developing a cost-effective and environmentally friendly approach for creating a ZnO nanocomposite. This synthesized ZnO-propolis composite holds promise as an effective antimicrobial material for potential use in forthcoming biomedical applications.
Data availability
The datasets used and/or analysed during the current study available from the corresponding author on reasonable request.
Abbreviations
- °C:
-
Degree celsius
- ANOVA:
-
Analysis of variance
- Cm:
-
Centimeter
- DNA:
-
Deoxyribonucleic acid
- RNA:
-
Ribonucleic acid
- EDX:
-
Energy dispersive X-ray
- FTIR:
-
Fourier transform infrared radiation
- G:
-
Gram
- L:
-
Liter
- MBC:
-
Minimum bactericidal concentration
- mg/l:
-
Milligrams to liter
- M–H agar:
-
Mueller–Hinton agar
- MIC:
-
Minimum inhibitory concentration
- Ml:
-
Milliliter
- Mm:
-
Millimeter
- NA:
-
Nutrient agar medium
- QE:
-
Quercetin equivalents
- ROS:
-
Reactive oxygen species
- SEM:
-
Scanning electron microscopy
- TEM:
-
Transmission electron microscopy
- XRD:
-
X-ray diffraction
- ZnO-NPs:
-
Zinc Oxide nanoparticles
- ZnO-P NCs:
-
Zinc Oxide -propolis nanocomposite
- Zp:
-
Zeta potential
References
Pennington, E. A Bioinformatic Pipeline for the Detection of Drug Resistant Mutations for Bacterial and Viral Pathogens (The George Washington University, 2023).
Mat Rahim, N., Lee, H., Strych, U. & AbuBakar, S. Facing the challenges of multidrug-resistant Acinetobacter baumannii: Progress and prospects in the vaccine development. Hum. Vaccin. Immunother. 17, 3784–3794. https://doi.org/10.1080/21645515.2021.1927412 (2021).
Labes, A. Marine resources offer new compounds and strategies for the treatment of skin and soft tissue infections. Mar. Drugs 21, 387. https://doi.org/10.3390/md21070387 (2023).
Huh, A. J. & Kwon, Y. J. “Nanoantibiotics”: A new paradigm for treating infectious diseases using nanomaterials in the antibiotics resistant era. J. Control. Release 156, 128–145. https://doi.org/10.1016/j.jconrel.2011.07.002 (2011).
Frei, A., Verderosa, A. D., Elliott, A. G., Zuegg, J. & Blaskovich, M. A. Metals to combat antimicrobial resistance. Nat. Rev. Chem. 7, 202–224. https://doi.org/10.1038/s41570-023-00463-4 (2023).
Madkhali, O. A. A comprehensive review on potential applications of metallic nanoparticles as antifungal therapies to combat human fungal diseases. Saudi Pharm. J. 31, 101733. https://doi.org/10.1016/j.jsps.2023.101733 (2023).
Vasistha, S., Khanra, A. & Rai, M. P. Influence of microalgae-ZnO nanoparticle association on sewage wastewater towards efficient nutrient removal and improved biodiesel application: An integrated approach. J. Water Process Eng. 39, 101711. https://doi.org/10.1016/j.jwpe.2020.101711 (2021).
Silva, H. et al. The cardiovascular therapeutic potential of propolis—A comprehensive review. Biology 10, 27. https://doi.org/10.3390/biology10010027 (2021).
Tavares, L., Smaoui, S., Lima, P. S., de Oliveira, M. M. & Santos, L. Propolis: Encapsulation and application in the food and pharmaceutical industries. Trends Food Sci. Technol. 127, 169–180. https://doi.org/10.1016/j.tifs.2022.06.003 (2022).
Saad, S., Abdel-Fattah, D., Khamis, T. & El-Sobky, A. Potential role of propolis nanoparticles in medicine and health: An updated review. Adv. Anim. Vet. Sci. 10, 589–598. https://doi.org/10.17582/journal.aavs/2022/10.3.589.598 (2022).
George, S. et al. Use of a rapid cytotoxicity screening approach to engineer a safer zinc oxide nanoparticle through iron doping. ACS Nano 4, 15–29. https://doi.org/10.1021/nn901503q (2010).
Vazhacharickal, P. J. A review on health benefits and biological action of honey, propolis and royal jelly. J. Med. Plants Stud. 9, 1–13. https://doi.org/10.1155/2017/1259510 (2021).
Jin, S.-E. & Jin, H.-E. Antimicrobial activity of zinc oxide nano/microparticles and their combinations against pathogenic microorganisms for biomedical applications: From physicochemical characteristics to pharmacological aspects. Nanomaterials 11, 263. https://doi.org/10.3390/nano11020263 (2021).
de Mello, L. B., Varanda, L. C., Sigoli, F. A. & Mazali, I. O. Co-precipitation synthesis of (Zn–Mn)-co-doped magnetite nanoparticles and their application in magnetic hyperthermia. J. Alloys Compd. 779, 698–705. https://doi.org/10.1016/j.jallcom.2018.11.280 (2019).
Parveen, K., Banse, V., Ledwani, L. Green synthesis of nanoparticles: Their advantages and disadvantages. In Proceedings of the AIP conference proceedings (2016).
Meda, A., Lamien, C. E., Romito, M., Millogo, J. & Nacoulma, O. G. Determination of the total phenolic, flavonoid and proline contents in Burkina Fasan honey, as well as their radical scavenging activity. Food Chem. 91, 571–577. https://doi.org/10.1016/j.foodchem.2004.10.006 (2005).
Chang, C.-C., Yang, M.-H., Wen, H.-M. & Chern, J.-C. Estimation of total flavonoid content in propolis by two complementary colorimetric methods. J. Food Drug Anal. 5, 120. https://doi.org/10.38212/2224-6614.2748 (2002).
Benkova, M., Soukup, O. & Marek, J. Antimicrobial susceptibility testing: Currently used methods and devices and the near future in clinical practice. J. Appl. Microbiol. 129, 806–822. https://doi.org/10.1111/jam.14704 (2020).
Wiegand, I., Hilpert, K. & Hancock, R. E. Agar and broth dilution methods to determine the minimal inhibitory concentration (MIC) of antimicrobial substances. Nat. Protoc. 3, 163–175. https://doi.org/10.1038/nprot.2007.521 (2008).
Salama, S. A. et al. Nano Propolis, Zinc Oxide Nanoparticles, and Their Composites: A Novel Green Synthesis with Synergistic Antioxidant and Anticancer Properties. J. Compos. Sci. 7, 480. https://doi.org/10.3390/jcs7110480 (2023).
Mohamad, A. A. et al. First-principles calculation on electronic properties of zinc oxide by zinc–air system. J. King Saud Univ. Eng. Sci. 29, 278–283. https://doi.org/10.1016/j.jksues.2015.08.002 (2017).
Suresh, S., Karthikeyan, S. & Jayamoorthy, K. Spectral investigations to the effect of bulk and nano ZnO on peanut plant leaves. Karbala Int. J. Mod. Sci. 2, 69–77. https://doi.org/10.1016/j.kijoms.2016.01.005 (2016).
Osman, M. S. et al. Effective inhibition of waterborne and fungal pathogens using ZnO nanoparticles prepared from an aqueous extract of propolis: Optimum biosynthesis, characterization, and antimicrobial activity. Appl. Nanosci. 13, 4515–4526. https://doi.org/10.1007/s13204-022-02726-w (2023).
Shahab-Navaei, F. & Asoodeh, A. Synthesis of optimized propolis solid lipid nanoparticles with desirable antimicrobial, antioxidant, and anti-cancer properties. Sci. Rep. 13, 18290. https://doi.org/10.1038/s41598-023-45768-y (2023).
Munoz, V. A., Ferrari, G. V., Sancho, M. I. & Montaña, M. P. Spectroscopic and thermodynamic study of chrysin and quercetin complexes with Cu (II). J. Chem. Eng. Data 61, 987–995. https://doi.org/10.1021/acs.jced.5b00837 (2016).
PP, V. In vitro biocompatibility and antimicrobial activities of zinc oxide nanoparticles (ZnO NPs) prepared by chemical and green synthetic route—A comparative study. BioNanoScience 10, 112–121. https://doi.org/10.1007/s12668-019-00698-w (2020).
Refaat, H., Mady, F. M., Sarhan, H. A., Rateb, H. S. & Alaaeldin, E. Optimization and evaluation of propolis liposomes as a promising therapeutic approach for COVID-19. Int. J. Pharm. 592, 120028. https://doi.org/10.1016/j.ijpharm.2020.120028 (2021).
da Silva, C., Prasniewski, A., Calegari, M. A., de Lima, V. A. & Oldoni, T. L. Determination of total phenolic compounds and antioxidant activity of ethanolic extracts of propolis using ATR–FT-IR spectroscopy and chemometrics. Food Anal. Methods 11, 2013–2021. https://doi.org/10.1007/s12161-018-1161-x (2018).
PD, D. A. et al. Synthesis of zinc oxide nanoparticles using methanol propolis extract (Pro-ZnO NPs) as antidiabetic and antioxidant. PLoS One 18, e0289125. https://doi.org/10.1371/journal.pone.0289125 (2023).
Clogston, J. D. & Patri, A. K. Zeta Potential Measurement. In Characterization of Nanoparticles Intended for Drug Delivery. Methods in Molecular Biology Vol. 697 (ed. McNeil, S.) 63–70 (Humana Press, 2011). https://doi.org/10.1007/978-1-60327-198-1_6.
Yousaf, S. et al. Tuning the structural, optical and electrical properties of NiO nanoparticles prepared by wet chemical route. Ceram. Int. 46, 3750–3758. https://doi.org/10.1016/j.ceramint.2019.10.097 (2020).
Mosnáčková, K., Chehimi, M. M., Fedorko, P. & Omastová, M. Polyamide grafted with polypyrrole: Formation, properties, and stability. Chem. Pap. 67, 979–994. https://doi.org/10.2478/s11696-012-0305-5 (2013).
Gupta, K., Jana, P. & Meikap, A. Optical and electrical transport properties of polyaniline–silver nanocomposite. Synth. Met. 160, 1566–1573. https://doi.org/10.1016/j.synthmet.2010.05.026 (2010).
Atta, A., Abdelhamied, M. M., Abdelreheem, A. M. & Berber, M. R. Flexible methyl cellulose/polyaniline/silver composite films with enhanced linear and nonlinear optical properties. Polymers 13, 1225. https://doi.org/10.3390/polym13081225 (2021).
Simon, P. & Gogotsi, Y. Materials for electrochemical capacitors. Nat. Mater. 7, 845–854 (2008).
Wang, R., Lang, J., Liu, Y., Lin, Z. & Yan, X. Ultra-small, size-controlled Ni(OH)2 nanoparticles: Elucidating the relationship between particle size and electrochemical performance for advanced energy storage devices. NPG Asia Mater. 7, e183–e183. https://doi.org/10.1038/am.2015.42 (2015).
Juneja, V. K., Dwivedi, H. P. & Yan, X. Novel natural food antimicrobials. Annu. Rev. Food Sci. Technol. 3, 381–403. https://doi.org/10.1146/annurev-food-022811-101241 (2012).
Nazoori, E. S. & Kariminik, A. In vitro evaluation of antibacterial properties of zinc oxide nanoparticles on pathogenic prokaryotes. J. Appl. Biotechnol. Rep. 5, 162–165. https://doi.org/10.29252/jabr.05.04.05 (2018).
Barthwal, S., Jeon, Y. & Lim, S.-H. Superhydrophobic sponge decorated with hydrophobic MOF-5 nanocoating for efficient oil–water separation and antibacterial applications. Sustain. Mater. Technol. 33, e00492. https://doi.org/10.1016/j.susmat.2022.e00492 (2022).
Siripatrawan, U. & Noipha, S. Active film from chitosan incorporating green tea extract for shelf life extension of pork sausages. Food Hydrocoll. 27, 102–108. https://doi.org/10.1016/j.foodhyd.2011.08.011 (2012).
Kim, G., Om, A., Mun, J. Nano-particle enhanced impedimetric biosensor for detedtion of foodborne pathogens. In Proceedings of the Journal of Physics: Conference Series, 555 (2007).
Zhao, G., Xing, F. & Deng, S. A disposable amperometric enzyme immunosensor for rapid detection of Vibrio parahaemolyticus in food based on agarose/nano-Au membrane and screen-printed electrode. Electrochem. Commun. 9, 1263–1268. https://doi.org/10.1016/j.elecom.2007.01.036 (2007).
Lin, C.-C. et al. Selective binding of mannose-encapsulated gold nanoparticles to type 1 pili in Escherichia coli. J. Am. Chem. Soc. 124, 3508–3509. https://doi.org/10.1021/ja0200903 (2002).
Almuhayawi, M. S. Propolis as a novel antibacterial agent. Saudi J. Biol. Sci. 27, 3079–3086. https://doi.org/10.1016/j.sjbs.2020.09.016 (2020).
Gonsales, G., Orsi, R., Fernandes Júnior, A., Rodrigues, P. & Funari, S. Antibacterial activity of propolis collected in different regions of Brazil. J. Venom. Anim. Toxins Incl. Trop. Dis. 12, 276–284. https://doi.org/10.1590/s1678-91992006000200009 (2006).
Bucio-Villalobos, C. M. & Martínez-Jaime, O. A. Antibacterial activity of aqueous extract of propolis from Irapuato, Guanajuato, Mexico. Agron. Mesoam. 28, 223–227 (2017).
Monzote, L. et al. In vitro antimicrobial assessment of Cuban propolis extracts. Memórias do instituto oswaldo cruz 107, 978–984. https://doi.org/10.1590/s0074-02762012000800003 (2012).
Dantas Silva, R. P. et al. Antioxidant, antimicrobial, antiparasitic, and cytotoxic properties of various Brazilian propolis extracts. PLoS One 12, e0172585. https://doi.org/10.1371/journal.pone.0172585 (2017).
Lambert, R. Susceptibility testing: Inoculum size dependency of inhibition using the Colworth MIC technique. J. Appl. Microbiol. 89, 275–279. https://doi.org/10.1046/j.1365-2672.2000.01105.x (2000).
Masschalck, B., Deckers, D. & Michiels, C. W. Lytic and nonlytic mechanism of inactivation of gram-positive bacteria by lysozyme under atmospheric and high hydrostatic pressure. J. Food Prot. 65, 1916–1923. https://doi.org/10.4315/0362-028x-65.12.1916 (2002).
Espitia, P. J. P. et al. Zinc oxide nanoparticles: Synthesis, antimicrobial activity and food packaging applications. Food Bioprocess Technol. 5, 1447–1464. https://doi.org/10.1016/b978-0-12-800723-5.00034-6 (2012).
Acknowledgements
The authors acknowledge the supported and funded by the Deanship of Scientific Research at Imam Mohammad Ibn Saud Islamic University (IMSIU) (grant number IMSIU-RP23091). Riyadh, Saudi Arabia.
Funding
This work was supported and funded by the Deanship of Scientific Research at Imam Mohammad Ibn Saud Islamic University (IMSIU) (grant number IMSIU-RP23091).
Author information
Authors and Affiliations
Contributions
Methodology, formal analysis, visualization, writing original draft: S.A.S., D.E., A.I.T., Project administration, supervision, funding acquisition, resources: W.N.H., A.A.F., M.Al.-Z., R.M., M.M., F.A.N. Conceptualization, software, writing original draft, validation: E.M.K., Y.F.A., A.A. Eweis was added to the list of authors for him valuable contribution in addressing the reviewers’ feedback regarding the NPs-bacterial cell surface interaction and the remarkable activity of composite and improvement the antimicrobial discussion section.
Corresponding author
Ethics declarations
Competing interests
The authors declare no competing interests.
Additional information
Publisher's note
Springer Nature remains neutral with regard to jurisdictional claims in published maps and institutional affiliations.
Rights and permissions
Open Access This article is licensed under a Creative Commons Attribution-NonCommercial-NoDerivatives 4.0 International License, which permits any non-commercial use, sharing, distribution and reproduction in any medium or format, as long as you give appropriate credit to the original author(s) and the source, provide a link to the Creative Commons licence, and indicate if you modified the licensed material. You do not have permission under this licence to share adapted material derived from this article or parts of it. The images or other third party material in this article are included in the article’s Creative Commons licence, unless indicated otherwise in a credit line to the material. If material is not included in the article’s Creative Commons licence and your intended use is not permitted by statutory regulation or exceeds the permitted use, you will need to obtain permission directly from the copyright holder. To view a copy of this licence, visit http://creativecommons.org/licenses/by-nc-nd/4.0/.
About this article
Cite this article
Salama, S.A., Essam, D., Tagyan, A.I. et al. Novel composite of nano zinc oxide and nano propolis as antibiotic for antibiotic-resistant bacteria: a promising approach. Sci Rep 14, 20894 (2024). https://doi.org/10.1038/s41598-024-70490-8
Received:
Accepted:
Published:
Version of record:
DOI: https://doi.org/10.1038/s41598-024-70490-8
Keywords
This article is cited by
-
ZnO nanoparticles in biomedical and agricultural applications: a review on double-edged sword of genotoxicity and therapeutic potential
Nanotechnology for Environmental Engineering (2026)
-
Nanostructured Delivery Systems Can Improve Propolis Antimicrobial Potential
Revista Brasileira de Farmacognosia (2025)